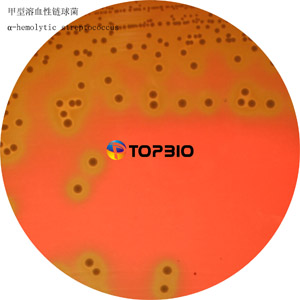

- 定做培養(yǎng)基/定制培養(yǎng)基
- 顆粒培養(yǎng)基
- 標(biāo)準(zhǔn)菌株生化鑒定試劑盒
- 預(yù)灌裝即用型成品培養(yǎng)基
- 2025年版中國(guó)藥典
- 促銷(xiāo)/特價(jià)商品
- 院感/疾控/體外診斷/采樣管
- 樣品采集與處理(均質(zhì))產(chǎn)品
- 按標(biāo)準(zhǔn)檢索培養(yǎng)基
- 模擬灌裝用培養(yǎng)基
- 干燥粉末培養(yǎng)基
- 細(xì)菌培養(yǎng)基
- 稀釋和樣品制備用培養(yǎng)基
- 生化鑒定用培養(yǎng)基
- 細(xì)菌保存用培養(yǎng)基
- 運(yùn)送培養(yǎng)基
- 藥敏試驗(yàn)用培養(yǎng)基
- 通用需氧和兼性厭氧菌培養(yǎng)基
- 大腸桿菌/大腸菌群
- 大腸埃希氏菌O157:H7/NM
- 阪崎腸桿菌/克羅諾桿菌
- 沙門(mén)氏菌屬/志賀氏菌屬
- 小腸結(jié)腸炎耶爾森氏菌/鼠疫桿菌
- 布魯氏菌屬
- 銅綠假單胞菌/假單胞菌屬
- 金黃色葡萄球菌/葡萄球菌屬
- 腸球菌屬/鏈球菌屬
- 單核增生李斯特氏菌/李斯特氏菌屬..
- 蠟樣芽胞桿菌/芽孢桿菌屬
- 炭疽桿菌屬
- 副溶血性弧菌/霍亂弧菌/弧菌屬
- 嗜水氣單胞菌/氣單胞菌屬
- 鏈霉菌屬/放線菌
- 結(jié)核分枝桿菌/分枝桿菌屬
- 嗜肺軍團(tuán)菌/軍團(tuán)菌屬
- 淋病奈瑟氏菌/奈瑟氏菌屬/嗜血桿..
- 百日咳桿菌
- 白喉?xiàng)U菌
- 磷細(xì)菌(肥料)
- 光合細(xì)菌
- 通用厭氧菌培養(yǎng)基
- 產(chǎn)氣莢膜梭菌/生孢梭菌/梭狀芽胞..
- 脆弱擬桿菌/擬桿菌屬
- 啤酒微生物檢測(cè)
- 空腸彎曲桿菌/彎曲桿菌屬
- 通用乳酸菌培養(yǎng)基
- 干酪乳桿菌/保加利亞乳桿菌/乳桿..
- 嗜熱鏈球菌
- 雙歧桿菌屬
- 幽門(mén)螺桿菌
- 固氮螺菌/固氮菌屬
- 根瘤菌屬
- 生物素/維生素測(cè)定培養(yǎng)基
- 其它細(xì)菌培養(yǎng)基
- 真菌培養(yǎng)基
- 顯色培養(yǎng)基
- 支原體培養(yǎng)基
- 植物組織培養(yǎng)基
- 疫苗培養(yǎng)基
- 分子生物/基因工程培養(yǎng)基
- 其它用途培養(yǎng)基
- 培養(yǎng)基添加劑/補(bǔ)充劑
- 生化反應(yīng)鑒定管
- 染色液等配套產(chǎn)品
- 對(duì)照培養(yǎng)基/標(biāo)準(zhǔn)品
- 實(shí)驗(yàn)耗材與器具
- 生化試劑/化學(xué)試劑
- 菌種鑒定服務(wù)
|
|
Beef Extract(牛肉浸粉) 3.0g
Sodium Chloride(氯化鈉) 5.0g
Agar(瓊脂) 15.0g
pH7.3±0.1(25℃)
1、理化檢驗(yàn)
|
檢驗(yàn)項(xiàng)目 |
檢驗(yàn)標(biāo)準(zhǔn) |
檢驗(yàn)結(jié)果 |
|
粉末外觀 |
淡黃色粉末,均勻無(wú)雜質(zhì) |
淡黃色粉末,均勻無(wú)雜質(zhì) |
|
溶液或膠體 |
淡黃色,透明無(wú)雜質(zhì) |
淡黃色,透明無(wú)雜質(zhì) |
|
凝膠強(qiáng)度 |
550~650g/cm2 |
640g/cm2 |
|
pH(25℃) |
7.3±0.1 |
7.33 |
|
水分 |
≤5% |
2.5% |
2、靈敏度測(cè)試(添加無(wú)菌脫纖維綿羊血,35±2℃培養(yǎng)48小時(shí))
|
質(zhì)控菌株 |
接種量 |
生長(zhǎng)情況 |
結(jié)論 |
|
大腸埃希氏菌 ATCC 25922 |
10-100CFU |
生長(zhǎng)良好, β溶血 |
合格 |
|
金黃色葡萄球菌 ATCC 25923 |
10-100CFU |
生長(zhǎng)良好,β溶血 |
合格 |
|
乙型溶血性鏈球菌 ATCC 21059 |
50-200CFU |
生長(zhǎng)良好,β溶血 |
合格 |
|
化膿性鏈球菌 ATCC 19615 |
50-200CFU |
生長(zhǎng)良好,α溶血 |
合格 |
|
腦膜炎奈瑟氏菌 ATCC 13090 |
50-200CFU |
生長(zhǎng)良好,γ溶血 |
合格 |
結(jié)論:產(chǎn)品理化和靈敏度均合格,產(chǎn)品合格
- 1. M4328 - 營(yíng)養(yǎng)鹽瓊脂培養(yǎng)基 Nutrient Salt Agar Medium
- 2. M9014 - N6培養(yǎng)基(不含瓊脂) N6 Medium by CHU(1975)without AgarChu N6 Medium without Agar
- 3. M2328 - 線蟲(chóng)生長(zhǎng)培養(yǎng)基/線蟲(chóng)生長(zhǎng)瓊脂培養(yǎng)基NGM培養(yǎng)基 Nematode Growth MediumNematode Growth Agar Medium
- 4. M1014 - 去氧膽酸鹽瓊脂(DC) Desoxycholate Lactose Agar
- 5. M0704 - 腦-心浸萃液態(tài)培養(yǎng)基 Brain-Heart Extraction Liquid Medium
- 6. M0563 - Hugh-Leifson培養(yǎng)基(不含葡萄糖) (O/F) Hugh-Leifson Medium without Dextrose
- 7. M8119 - Iso-Sensitest瓊脂 Iso-Sensitest Agar
- 8. M1551 - MRS瓊脂 MRS Agar(de Man, Rogos,Sharpe)
- 9. M4191 - 毛蘚菌瓊脂3號(hào) Trichophyton Agar #3
- 10. M4158 - 曲霉素瓊脂(AFPA)基礎(chǔ) AFPA Agar Base



